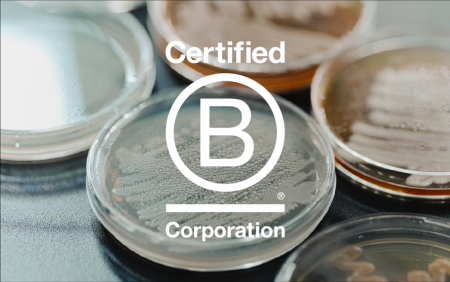
株式会社ファーメンステーション、121.5点のスコアでB 株式会社ファーメンステーション、121.5点のスコアでB

株式会社ファーメンステーション、121.5点のスコアでB Corp認証を更新
株式会社ファーメンステーション
再認証を通過点とし、事業と社会的インパクトの両立を加速
[画像:
https://prcdn.freetls.fastly.net/release_image/51332/117/51332-117-1ee49960b32cb1fdf8a648bbfbd68ef3-1046x656.png?width=536&quality=85%2C75&format=jpeg&auto=webp&fit=bounds&bg-color=fff ]
独自の発酵技術で未利用資源を再生・循環させる社会を構築する研究開発型スタートアップの株式会社ファーメンステーション(以下、ファーメンステーション。本社:千葉県船橋市、代表取締役:酒井 里奈)は、国際的な企業認証制度「B Corp(ビーコープ)」の審査において再認証を受けました。B Corpは、環境や社会への配慮、ステークホルダーとの関係性、経営の透明性、事業の持続可能性などを総合的に評価する認証制度で、3年ごとに再審査が行われます。
初回認証時(2022年)の82.2点に対し、今回の再認証では121.5点のスコアとなりました。今回の結果は、認証取得以降に取り組んできた改善と成長を反映したものです。
ガバナンス 11.3/20点
社員 23.2/40点
コミュニティ 23/70点
環境 45.2/105点
顧客 4.1/5点
■再認証の評価ポイント
・未利用資源を活用ていることに加え、発酵プロセスそのものの環境負荷の低さで評価を得られた。LCAの実施で環境負荷を認識・管理・改善していることに説得力があった。
・事業共創により、他社の環境インパクトを低減しうるビジネスモデルが評価された。当社の意図するインパクトのスコープを明確にし、社会性を優先したこと(例:原材料が未利用資源でない案件はお断りする)などが評価に繋がった。
・全社でインパクトを追求し、学び、対外的に共有、公開している点
など
B Corpとは
「B Corporation(TM)︎(以下、B Corp)」は、2006年にアメリカで始まった、ビジネスを通じて社会を変えるムーブメントです。企業の認証制度をメインに、世界102カ国以上の国に拡がり、様々な変革をリードしてきました。日本では2025年7月時点で60社以上が取得していることに加えて、パタゴニア、オールバーズ、ダノンといったグローバル企業との連携のもと徐々に認知が拡大し、様々な業種で注目を集めつつあります。
日本では2024年に「B Market Builder Japan」が発足し、ムーブメントを主導しています。
「インパクトレポート」について
当社は「Fermenting a Renewable Society(発酵の力で循環する社会を)」をパーパスに掲げ、未利用資源を再生・循環させる社会を目指しています。
多様な微生物を駆使した高度な発酵技術を用い、食品廃棄物を高付加価値な機能性原料へアップサイクルすることで、フードロス削減と循環型社会の実現に貢献することを目的としています。
事業性と社会性の両立を目指す企業として、年に1回、事業活動による社会的インパクトを振り返る「インパクトレポート」を発行しています。
2024年版では、新たなインパクトモデル(β版)を策定するなど、当社が与える社会的影響の可視化を行っています。
2024年版のインパクトレポートはこちら
https://fermenstation.co.jp/report/
尺度としてのB Corp認証
B Corp認証は、地域社会・環境・顧客・従業員など多様なステークホルダーに対する価値創出を評価し、客観的な基準と定点チェックを提供します。当社にとってB Corpは、持続的に社会的インパクトを拡大するための「ものさし」です。B Corpのスコアはあくまで活動を客観的に確認する尺度に過ぎず、本質は事業活動を通じて社会や環境にポジティブなインパクトを生み続けることにあります。今回の再認証を機に、さらに事業性と社会性の両立を深め、循環型社会の実現に向けて歩みを加速して参ります。
■事業について
昨今、食品ロス/食品製造工程で生じる残さ・余剰農産物などをはじめとした未利用バイオマスの有効活用は、持続可能な未来に向けたグローバルな課題です。
しかし、それぞれに多種多様な特徴を持つ未利用バイオマスと、目的の機能や特性を有するアップサイクル素材(化粧品・食品原料)を結びつける手段は豊富ではありません。
ファーメンステーションでは多様な微生物を駆使した高度な発酵技術を活用して、パートナー企業と共に食品・飲料工場の製造過程等で出る副産物・食品残さ等の未利用バイオマスを高付加価値な機能性バイオ素材へとアップサイクルする事業共創を展開しております。
技術に関する詳細はこちら
https://fermenstation.co.jp/technology/
事業共創に関する詳細はこちら
https://fermenstation.co.jp/collabo/
<株式会社ファーメンステーションについて>
ファーメンステーションは「Fermenting a Renewable Society(発酵で楽しい社会を!)」をパーパスに、未利用資源を再生・循環させる社会の構築を目指すバイオものづくりスタートアップです。独自の未利用バイオマス・微生物データベースと発酵アップサイクル技術を活用し、フードロス/ウェイストおよびその他未利用バイオマス由来のバイオ素材を開発・製造しています。発酵アップサイクル技術の基盤と、開発するアップサイクル原料をもとに、化粧品等の原料製造・販売を行う「原料事業」、パートナー企業と共創し食品・飲料工場の製造過程等で出る副産物・食品残さ等をアップサイクルしたバイオ素材等を開発する「事業共創」等を展開しています。
岩手県奥州市に自社工場を持つことで、開発から製造まで一気通貫で対応可能であり、製造過程で生じる発酵副産物を化粧品原料や地域の鶏や牛の飼料として最大限利用することで、可能な限り廃棄物を少なくする循環型モデルを構築し、地域循環型社会の形成にも取り組んでおります。
また、地域社会、環境、カスタマー、従業員に対して多面的・包括的な利益を生む事業活動を実践する企業を認証する国際的な制度「B Corp 認証」を取得しており、経済産業省から「J-Startup」「J-Startup Impact」に選定されています。
会社名 : 株式会社ファーメンステーション / Fermenstation Co.,Ltd.
代表者 : 代表取締役 酒井 里奈
所在地 : 〒273-0864 千葉県船橋市北本町1丁目17番25号
事業内容 : 発酵アップサイクル技術を活用した未利用バイオマス(フードロス等)由来のバイオ素材の研究開発および製造販売、独自技術・ノウハウを活用した事業共創・共同研究開発、アップサイクル原料を活用した化粧品・雑貨OEM/ODM
コーポレートサイト :
https://fermenstation.co.jp/
事業共創 :
https://fermenstation.co.jp/collabo/
技術 :
https://fermenstation.co.jp/technology/
このニュースに関するお問い合わせは、下記までお願いいたします。
株式会社ファーメンステーション 渡辺 麻貴
E-mail:info@fermenstation.jp
プレスリリース提供:PR TIMES
記事提供:PRTimes